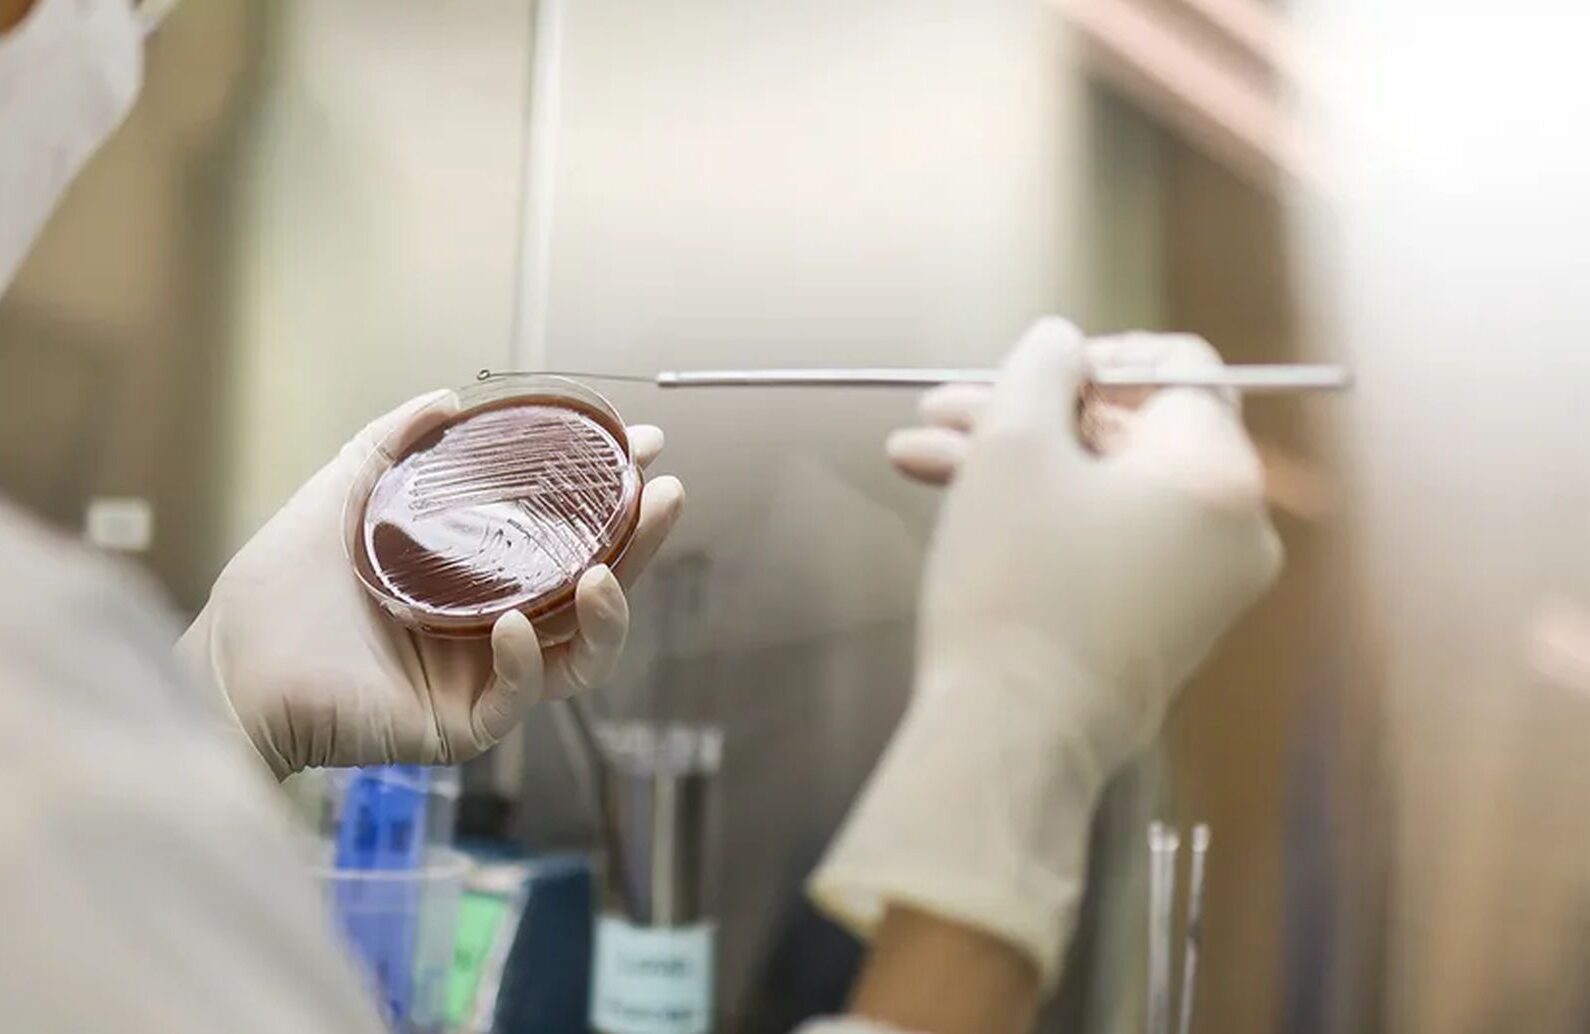
Gonoreja i hlamidija, a ne vaginalna gljivična ili bakterijska infekcija, kako da razlikujemo ova stanja

FOTO: SHUTTERSTOCK
FOTO: SHUTTERSTOCK
Gonoreja i hlamidija, a ne vaginalna gljivična ili bakterijska infekcija, kako da razlikujemo ova stanja
16.04.2026. | 22:37Svrab, peckanje, iritacija, gust vaginalni sekret neprijatni su i dosta česti simptomi najčešće vaginalne gljivične infekcije, bakterijske vaginoze, ali i alergije i iritacija, na primjer agresivnim sredstvima za higijenu.
Vaginalna gljivična infekcija je učestao zdravstveni problem i posljedica prekomjernog razmnožavanja gljivica, najčešće Candida.
Ova infekcija je uglavnom bezopasna, ali praćena je tegobama koje zahtijevaju poseban oprez jer mogu da se jave i kod polno prenosivih bolesti, ali i oboljenja kože kao što je psorijaza.
Slične tegobe, različito liječenje
Moguće je da imamo gonoreju i hlamidiju, a ne samo vaginalnu gljivičnu infekciju, upozoravaju ljekari. Dosta slični simptomi nikada nisu razlog da nagađamo i da dajemo nestručne dijagnoze na osnovu jednog teksta, koji je u ovom slučaju samo upozorenje da se javimo ljekaru ako imamo mogući zdravstveni problem. Ako se simptomi često vraćaju ili nisu tipični, važno je da dođemo na pregled radi tačne dijagnoze.
Mnoge vaginalne tegobe mogu da imaju slične simptome, ali da zahtijevaju različito liječenje.
Vaginalna gljivična infekcija je česta infekcija koja izaziva peckanje, svrab, gust, beo sekret nalik na sir i nelagodnost u genitalnoj regiji. Mnoge druge tegobe mogu da liče na gljivičnu infekciju. Zato je uvijek važno da o simptomima razgovaramo sa svojim ljekarom – rekla je dr Dženifer Nelson, Banner – University Medicine.
Kako izgleda gljivična infekcija?
Vaginalna gljivična infekcija obično izaziva: svrab i iritaciju, peckanje, gust, beo sekret, nelagodnost u genitalnoj regiji. Problem je što navedeni simptomi mogu da se preklapaju sa drugim stanjima koja imaju različite uzroke.
Polno prenosive infekcije
Polno prenosive infekcije mogu da izazovu simptome slične gljivičnoj infekciji.
Polno prenosive infekcije često mogu da liče na gljivične infekcije, jer mogu da izazovu vaginitis, odnosno iritaciju vagine. Uobičajeni simptomi uključuju vaginalni sekret, svrab, peckanje, bol tokom seksualnog odnosa, krvarenje i neprijatan miris – navodi dr Nelson.
Najčešće polno prenosive infekcije koje mogu da izazovu ove simptome su:
Trihomonijaza: često bez simptoma, ali može da izazove svrab, peckanje, sekret ili bol tokom odnosa
Gonoreja i hlamidija: pojačan sekret, peckanje ili bol u donjem dijelu stomaka
Mycoplasma genitalium: pojačan sekret, krvarenje ili bol tokom odnosa
U zavisnosti od seksualnih navika, simptomi se mogu javiti i u rektalnoj ili oralnoj regiji.
Polno prenosne infekcije obično se liječe antibioticima. Pošto mnoge od ovih prenosnih bolesti mogu da budu bez simptoma, redovni pregledi i ginekološki pregledi su važni.
Bakterijska vaginoza
Bakterijska vaginoza je jedan od najčešćih uzroka vaginalnog sekreta i često se pogrešno smatra gljivičnom infekcijom.
Bakterijska vaginoza je posljedica poremećaja ravnoteže bakterija u vagini. Umjesto „dobrih“ bakterija (laktobacila), počinju da preovlađuju druge bakterije – rekla je dr Nelson.
Simptomi su: redak, beličast sekret, jak, neprijatan miris nalik na ribu. Bakterijska vaginoza nije isključivo polno prenosiva infekcija, ali rizik je veći kod pojačano seksualno aktivnih osoba sa više partnera. Obično se liječi antibioticima.
Alergijske reakcije ili iritacija (neinfektivni vaginitis)
Vaginalna regija je osjetljiva i može burno da reaguje na proizvode koje koristimo za higijenu.
Kao i drugi dijelovi tijela, vulva i vagina mogu da razviju kontaktni dermatitis kao reakciju na deterdžente, losione, sapune i kreme. Ovi proizvodi takođe mogu da promijene vaginalni pH i povećaju rizik od infekcija, objašnjava dr Nelson.
Simptomi su svrab, peckanje, sekret. Ključno je prepoznati i izbjegavati iritant. U nekim slučajevima mogu pomoći kratkotrajne terapije lokalnim steroidima.
Kožna oboljenja koja zahvataju vulvu
Određena kožna oboljenja mogu da liče na simptome gljivične infekcije. Ova stanja uključuju: ekcem, psorijazu, lichen sclerosus (lihensklerozus). Lihensklerozus često izaziva jak svrab i češći je nakon menopauze, obično se liječi kortikosteroidnim mastima i zahtijeva praćenje.
Zbog preklapanja simptoma, teško je da samostalno utvrdimo o čemu je riječ.
Uopšteno govoreći, gljivične infekcije su praćene gustim, bijelim sekretom i intenzivnim svrabom, bakterijske vaginoze rijetkim sekretom sa neprijatnim mirisom, kod polno prenosivih infekcija moguć je bol, krvarenje ili neobičan sekret.
Ipak, gljivična vaginalna infekcija i bakterijska vaginoza mogu da se pomiješaju, nekada su simptomi slični polno prenosivim bolestima, zbog čega je bitno testiranje, prenosi “eKlinika“.





